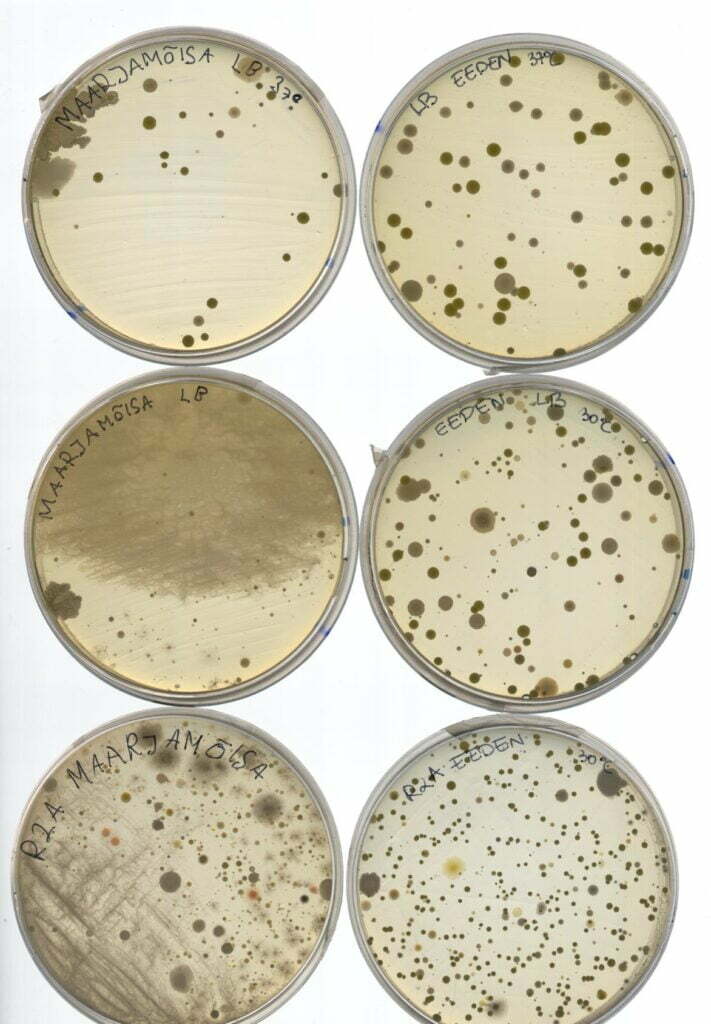

Meie kooli õpilased olid väga edukad õpilasuurimuste vabariiklikel konkurssidel.
Keskkonnaalaste uurimistööde konkursil pääsesid lõppvooru kümne osaleja hulka lausa kolm meie 12. kl õpilast: Paula Palmet (12.ME, juhendajad: Urmas Tokko ja Mariliis Hinnu, TÜ TI), Lii Lopp (12.LO, juhendajad Ott Maidre ja Kuno Kasak, TÜ), Raffael Somelar (12.LO, juh: U.Tokko ja Kaia Kask, EMÜ). Lõppvoorus pälvis Lii 2. koha, Paula 5. ja Raffael 7. koha. Konkurssi korraldas Tartu Loodusmaja koostöös Eesti Teadusagentuuriga (ETag).
Õpilaste teadustööde riiklikul konkursil jõudsid sadadest osalejatest 55 parima hulka (sh kõigi ainevaldkondade ja ka põhikooliõpilaste tööd) Raffael ning Elisabeth Dubova ja Laura Movits (12.LO, juhendajad Margit Kull (TTG) ja Külli Jaako, TÜ farmakoloogia osakond).
Võidukate tööde teemad on järgmised:
Lii: Põllumajanduse mõju veekvaliteedile ja avaveelise tehismärgala veepuhastuse efektiivsus.
Paula: Tartu bussipeatuste mikroobikoosluse uurimine: aastaajaline võrdlus ja panus ülemaailmsesse MetaSUB projekti.
Raffael: Temperatuuri tõusu ja mehaanilise vigastuse mõju lenduvühendite emissioonile käharas lehtkapsas (Brassica oleracea var. sabellica).
Elisabeth ja Laura: D-vitamiini aktiivvormi ja selle analoogi mõju närvirakkude elulemusele ja jätkete kasvule.
Suur tänu ja palju õnne, head õpilased, oleme teiega koos rõõmsad ja teie üle uhked!
• Pildid on pärit vastavatest uurimistöödest.
Uudise edastas õp Urmas Tokko